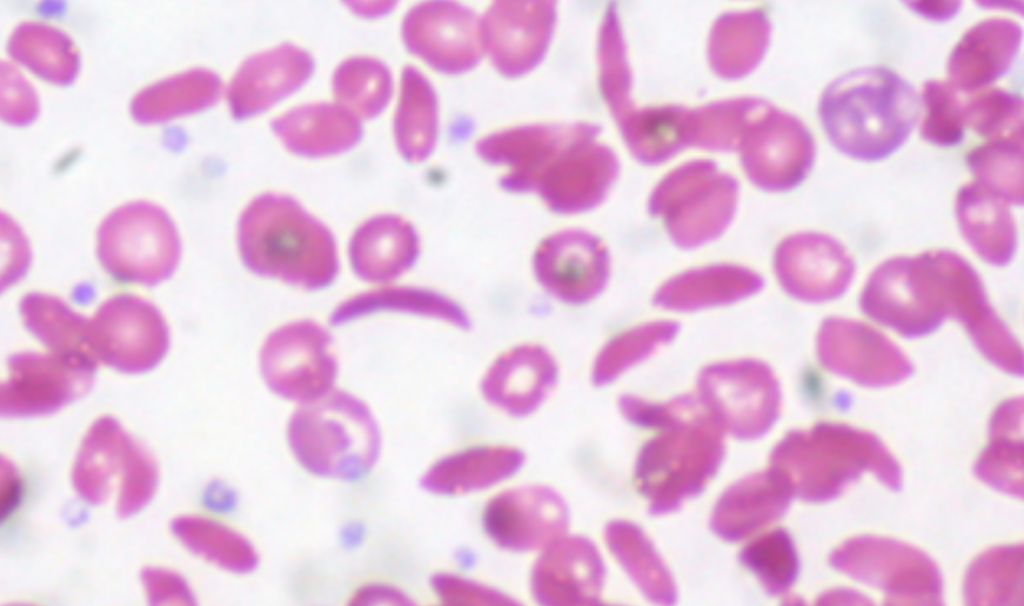

Iron is one of the most misunderstood minerals in the human body. Too little iron can cause fatigue, weakness, hair loss, and poor oxygen delivery. Too much iron can accelerate oxidative stress, inflammation, tissue damage, and aging. Yet many people struggle with an iron imbalance even when their diet appears adequate. What is often overlooked is this: iron is not just a human nutrient; it is also a microbial fuel. Many pathogens actively hijack iron, hoard it, and lock it away inside biofilms and infected tissues. This creates a paradox where people can appear iron-deficient on blood tests while simultaneously experiencing iron-driven inflammation and oxidative stress at the tissue level.
Chlorine dioxide (CD/CDS) is now being explored as a supportive upstream tool for iron management; not by adding or removing iron directly, but by reducing the microbial and biofilm burden that disrupts iron distribution and utilization.
- What Is Iron Mismanagement?
Iron mismanagement occurs when iron is:
-
- Poorly absorbed
- Improperly transported
- Sequestered by pathogens
- Trapped in inflamed tissues
- Unavailable for red blood cell production
- Contributing to oxidative stress
This leads to confusing symptom patterns such as:
-
- Fatigue despite “normal” iron labs
- Anemia that does not respond to supplements
- Brain fog
- Shortness of breath
- Cold intolerance
- Inflammation
- Point stiffness
- Premature aging
- Liver stress
Iron problems are often distribution problems, not intake problems.
- Why Do Pathogens Disrupt Iron Balance?
Microbes require iron to survive and replicate. To secure it, many pathogens:
-
- Secrete iron-binding compounds (siderophores)
- Pull the iron out of the host tissues
- Trap iron inside biofilms
- Trigger inflammation that alters iron metabolism
- Disrupt ferritin and transferrin balance
As a defensive response, the human body often hides iron during infection, a process known as nutritional immunity. While protective in the short term, this can cause long-term iron dysregulation when infections become chronic.
The result:
-
- Iron becomes unavailable where it’s needed
- Oxidative stress increases where iron accumulates improperly
- Who Might Benefit From Supporting Iron Balance via CD?
People who experience:
-
- Chronic fatigue
- Unexplained anemia
- Iron supplements that “don’t work.”
- Inflammation with normal iron labs
- Frequent infections
- Mold exposure
- Gut issues
- Liver congestion
- Brain fog
- Premature aging
- Low exercise tolerance
Iron imbalance often appears alongside chronic microbial burden, even when standard tests look inconclusive.
- Where Does Chlorine Dioxide Influence Iron Management?
Chlorine dioxide does not add iron or chelate iron directly.
Its proposed role is environmental cleanup:
1. Reducing Iron-Stealing Pathogens
Fewer microbes = less iron hijacking.
2. Breaking Down Biofilms That Trap Iron
Biofilms act like vaults that lock iron away from normal metabolism.
3. Reducing Inflammation That Alters Iron Signaling
Inflammation disrupts hepcidin, ferritin, and transferrin dynamics.
4. Improving Gut Environment
A healthier gut absorbs and regulates iron more effectively.
5. Supporting Liver Function
The liver regulates iron storage and recycling; reducing toxic load helps restore balance.
6. Improving Oxygenation
Better oxygen delivery improves iron utilization efficiency.
- When Does CD Become Relevant for Iron Regulation?
CD becomes particularly interesting when:
-
- Iron Labs fluctuates unpredictably
- Fatigue persists despite supplementation
- Inflammation markers remain elevated
- Infections are chronic or recurring
- Gut health is compromised
- Oxidative stress increases
- Aging accelerates without explanation
In these cases, iron imbalance may be secondary to microbial burden rather than nutritional deficiency.

How Chlorine Dioxide Supports Better Iron Utilization
- Reducing Microbial Iron Theft
Many pathogens require iron to thrive. Reducing microbial load may free iron for human use.
- Breaking Down Iron-Binding Biofilms
Biofilms trap iron, preventing proper circulation. CD weakens these structures.
- Lowering Inflammatory Signals
Inflammation alters iron transport proteins. Reducing microbial triggers helps normalize signaling.
- Supporting Red Blood Cell Efficiency
With cleaner tissues and better oxygenation, iron can be used more effectively.
- Reducing Oxidative Stress
Free iron in inflamed tissues catalyzes oxidative damage. Reducing inflammation lowers this risk.
- Improving Gut Absorption Environment
A balanced gut microbiome supports healthy iron uptake and regulation.
- Supporting Liver-Mediated Iron Recycling
The body recycles iron efficiently when the toxic burden is reduced.
Iron, Aging, and Longevity
Iron mismanagement is a major contributor to aging:
-
- Excess iron accelerates oxidative damage
- Trapped iron fuels chronic inflammation
- Iron-driven free radicals damage mitochondria
- Iron overload is linked to neurodegeneration
Proper iron balance is associated with:
-
- better energy
- clearer thinking
- improved oxygen delivery
- slower aging
- healthier immune function
By addressing microbial and inflammatory interference, chlorine dioxide may help restore iron balance naturally, without forcing iron levels up or down artificially.

Quick How-To Guide
- Avoid Blind Iron Supplementation
Excess iron can worsen oxidative stress if microbes are present.
- Support Microbial Reduction First
Many explore CD before adjusting iron intake.
- Hydration Is Essential
Iron transport depends on proper fluid balance.
- Support Liver and Gut
Magnesium, trace minerals, and gentle detox support iron regulation.
- Monitor Symptoms, Not Just Labs
Energy, stamina, clarity, and endurance often improve before numbers shift.
- Combine With Movement
Exercise improves iron utilization and oxygen delivery.
Disclaimer
This article is for informational and research purposes only. It does not diagnose, treat, cure, or prevent disease. Chlorine dioxide is not approved for internal therapeutic use by regulatory agencies. Iron metabolism is complex; always consult qualified professionals before making changes to supplementation or health practices.